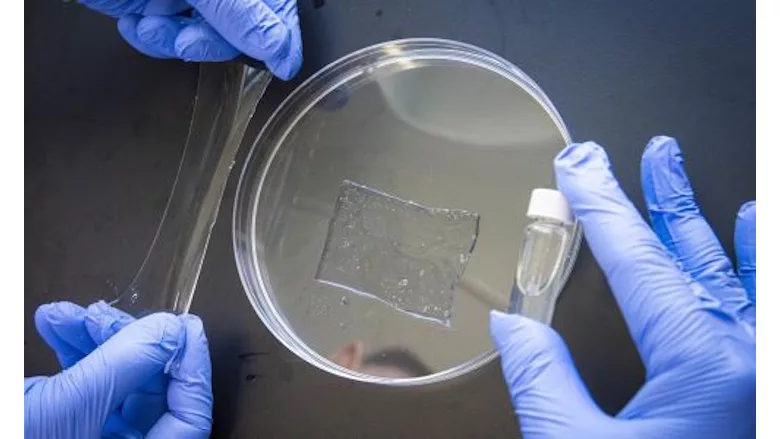
Gloved hands holding a petri dish with a rectangle of transparent stretchy material

Worcester Polytechnic Institute Researcher Is Developing Bio-adhesives for Long-Term Medical Implants
In Jiawei Yang's laboratory, researchers display a vial of clear liquid, a petri dish, and a transparent stretchy material. Image courtesy of Worcester Polytechnic Institute.
A Worcester Polytechnic Institute (WPI) researcher is developing a new class of medical adhesives by bringing together hydrogels and glue-like polymers to safely and reliably connect human tissues to therapeutic devices implanted in the body, such as pacemakers, insulin pumps, and artificial joints.
Jiawei Yang, an assistant professor in the Department of Mechanical and Materials Engineering who is affiliated with the Department of Biomedical Engineering, has received a CAREER Award from the National Science Foundation to create bio-adhesives that can provide strong, stable adhesion and comply with the mechanical demands on biological tissues.
“Medical devices and human beings are made of very different materials,” said Yang. “Medical devices are mostly made of hard materials, such as metal or plastic. Human tissue is generally soft and wet. There is a critical need for better adhesives that are soft and wet, like human tissues, to knit together tissues and devices. Better adhesives can work better with the body and would significantly improve healthcare and quality of life for patients.”
Yang will develop bio-adhesives with two layers — a transparent solid hydrogel layer and a clear liquid adhesive layer. Yang will develop a modular system of hydrogels that are tailored to the mechanical properties of target tissues and polymers that can merge with human tissues. Together, the hydrogel-polymer bio-adhesives will provide fast, strong, stable, and deep adhesion in the body.
As part of his five-year project, Yang will collaborate with Dr. Steffen Pabel at Massachusetts General Hospital to develop a hydrogel heart patch loaded with medications to treat atrial fibrillation, a type of irregular heartbeat. He also will create education and research programs about hydrogels for children and college students.
“There are many potential applications for new bio-adhesives,” Yang said. “They might be used to pair with electrodes that are implanted in the body to treat Parkinson’s disease or manage and treat heart failure. They also could be combined with therapeutic agents to heal damaged cartilage or generate healthy new tissues.”
Hydrogel bio-adhesives have been mostly used in emergency medicine to temporarily patch injuries, close wounds, and seal tissues. Yet they are less suited to long-term use in the body, specifically in implantation, because they cannot provide strong and stable adhesion while matching the mechanical properties of target tissues in the body, Yang said.
“Mechanical properties of human tissues vary significantly. Brain tissue is extremely soft and needs an extremely soft hydrogel, while a hydrogel used with cartilage needs to be stiff enough to flex and bear weight,” Yang said. “One size does not fit all when it comes to bio-adhesives.”
Looking for a reprint of this article?
From high-res PDFs to custom plaques, order your copy today!





